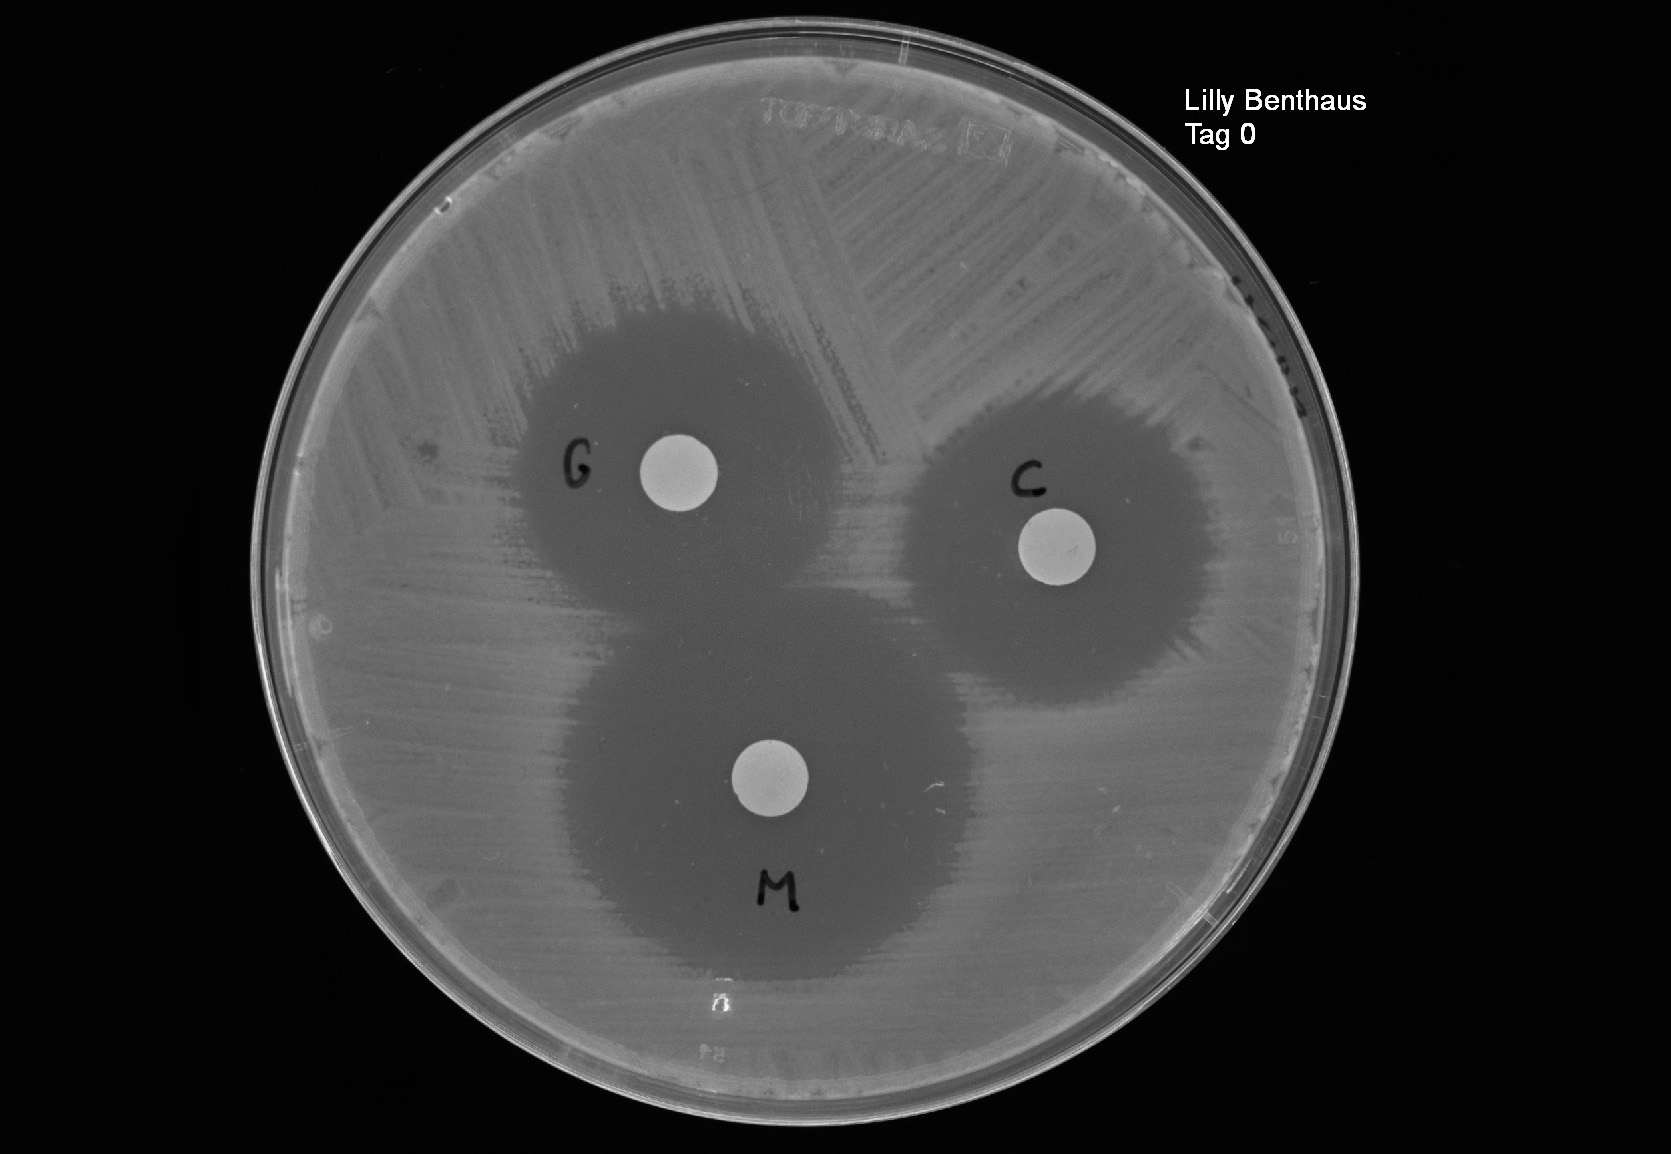

Lilly Benthaus: Tag 0 Aufnahme
Laborwerte
Im Folgenden schauen wir uns das Blutbild von Lilly an Tag 0 bei der Aufnahme an. Aus Patientenblutproben werden die wichtigsten Parameter bestimmt, um mögliche Krankheitsursachen einzugrenzen. Im Folgenden findest du zunächst Erklärungen der einzelnen Parameter:

Erythrozyten sind die roten Blutkörperchen. Hat man zu wenig davon, führt dies zu Problemen beim Sauerstofftransport. Zu viele Erythrozyten sind ein seltener Befund, außer bei langandauernden Lungenerkrankungen oder einigen Knochenmarkserkrankungen.
Leukozyten sind die weißen Blutkörperchen. Sie sind ein Sammelbegriff für alle Zellen im Blut, die für die Immunabwehr verantwortlich sind. Bei einer Infektion steigt die Leukozytenzahl sehr schnell an, und je schwerer die Infektion ist, desto höher ist der Wert.
Thrombozyten sind die Blutplättchen. Sie sind verantwortlich für die Blutgerinnung bei Verletzungen und können aus vielfältigen Gründen erhöht oder erniedrigt sein.
Natrium ist das wichtigste Kation im Blut. Natrium macht einen Teil des osmotischen Drucks des Blutes aus und hat damit Einfluss auf die Wassermenge im Blut. Bei zu hohem oder niedrigem Natrium kommt es schnell zu Umverteilungen des Körperwassers, was lebensbedrohlich sein kann.
Kalium ist wichtig für die Leitfähigkeit von Nerven- und Muskelzellen. Zu viel oder zu wenig Kalium im Blut löst Herzrhythmusstörungen aus. Der Spiegel wird vom Körper sehr eng kontrolliert, kann aber durch Medikamente leicht aus dem Gleichgewicht gebracht werden.
Der Blutzuckerwert gibt an, wieviel Glukose im Blut ist. Glukose ist der primäre Energielieferant für fast alle Zellen. Der Blutspiegel wird durch Insulin und zahlreiche weitere Hormone kontrolliert. Bei Diabetes mellitus ist diese Regulation gestört und der Blutzuckerspiegel zu hoch. Sehr hohe Blutzuckerspiegel können tödlich sein.
Das C-reaktive Protein (CRP) ist ein Protein der akuten Infektabwehr. CRP wird nach Erkennen einer Infektion durch das Immunsystem aus der Leber freigesetzt und hilft bei der Infektabwehr mit. Es hat sich als wichtigster Infektionsmarker im Blut in der medizinischen Diagnostik etabliert.
Als O2-Sättigung bezeichnet man den Anteil des mit Sauerstoff gesättigten Hämoglobins im Blut. Dieser Wert zeigt an, wie gut Lungen und Atmung den Körper mit Sauerstoff versorgen können. Bei chronischen Lungenerkrankungen können die Werte dauerhaft niedrig sein (< 85%), ohne dass der Patient Symptome bemerkt. Unterhalb von 80% wird die Organfunktion gestört, unter 60% setzt Bewusstlosigkeit ein.
Labor
Hier findest du die Laborwerte von Lilly Benthaus bei der Aufnahme an Tag 0. In der Spalte Normbereich findest du die normalen Werte. Kreuze an, ob Lilly´s Werte als auffällig zu bewerten sind.
| Parameter | Normbereich | Einheit | Aufnahme | auffällig |
| Erythrozyten | 4,3 – 5,75 | x 10^12/l | 4,7 | |
| Leukozyten | 3,9 – 10,2 | x 10^9/l | 11,5 | |
| Thrombozyten | 150 – 370 | x 10^9/l | 240 | |
| Natrium | 136 – 145 | mmol/l | 140 | |
| Kalium | 3,5 – 4,5 | mmol/l | 4,0 | |
| Blutzucker | 2,76 – 5,89 | mmol/l | 4,3 | |
| C-reaktives Protein | < 5,0 | mg/l | 7,8 | |
| O2-Sättigung | > 94 | % | 96 |
Lungenfunktion
Im Folgenden schauen wir uns die Untersuchung von Sauerstoffaufnahme, Atemvolumina und Bronchialsystem mit Hilfe verschiedener Geräte an. Da diese Werte stark vom Patienten abhängen (Alter, Geschlecht, Größe), gibt es keine allgemeingültigen Normalwerte. Stattdessen wird angegeben, wie nah die Ergebnisse am Erwartungswert des individuellen Patienten sind. Dabei gelten Werte zwischen 80 und 100% als normal. Für die routinemäßige Erfassung der Lungenfunktion bei Mukoviszidose sind zwei Werte besonders wichtig:

Das Luftvolumen zwischen der tiefstmöglichen Ein- und Ausatmung, also der größte Atemzug, den die Patientin/ der Patient machen kann. Der Wert weist auf eine eventuelle Einschränkung des Lungenvolumens hin, gibt aber keine Information über die Ursache. Der Wert kann bei fortgeschrittener Zerstörung der Lunge durch Rauchen oder Infektion verändert sein.
Das Luftvolumen, das bei der schnellstmöglichen Ausatmung in einer Sekunde die Lunge verlässt. Reduzierte Werte deuten auf ein Störung des Luftflusses in den Bronchien hin und treten klassischerweise bei Erkrankungen, die die Bronchien einengen auf, wie Asthma bronchiale oder Mukoviszidose. Die FEV1 wird bei der Mukoviszidose als schneller Test für den akuten Lungenzustand genutzt, da z.B. eine große Menge Sekret den Wert reduziert.
Du findest hier die Lungenfunktionswerte von Lilly Benthaus bei der Aufnahme an Tag 0. Der Normbereich liegt bei 80-100%. Kreuze an, ob Lilly’s Werte als auffällig zu bewerten sind.
Lungenfunktion (Normalbereich 80 – 100%)
| Parameter | Aufnahme | % der Norm | auffällig |
| VC | 3,60 L | 92 | |
| FEV1 | 2,53 L | 69 |
Mikrobiologischer Befund
Dichte auf Agar & Keimlast
Im Folgenden betrachten wir drei Parameter:

Die genaue Bestimmung der Bakterienspezies wird heutzutage mit komplizierten, aber sehr schnellen, massenspektrometrischen Methoden durchgeführt. Die Bestimmung ist wichtig, da sich daraus die Vorauswahl an Antibiotika ergibt, denn nicht alle Antibiotika wirken gegen alle Bakterien. Die endgültige Wahl des Medikaments erfolgt auf der Basis der Resistenzbestimmung und der Patientenangaben (z.B. Allergien).
Hierbei handelt es sich um eine grobe Angabe der bakteriellen Zellzahl auf der Agarplatte in Kategorien wie „massiv“, „reichlich“, „einige“ oder „vereinzelt“.
Bei der Keimlast handelt es sich um die genauere Bestimmung der bakteriellen Zellzahl pro Milliliter Material. Diese kann durch Zählen der Kolonien oder durch quantitative molekularbiologische Methoden bestimmt werden.
Material: Sputum
Fragestellung: Erreger
Kulturergebnisse:
| Tag | Erreger | Dichte auf Agar | Keimlast (Zellen/ml) |
| Aufnahme | Pseudomonas aeruginosa | reichlich | 2 x 10^5 |
Resistenzbestimmung mit dem Kirby-Bauer-Test
Nach der Identifikation wird das Bakterium gegen die potentiellen Antibiotika getestet. Wenn ein Medikament im Labor nicht mehr genug Bakterien abtöten, gilt der Stamm als resistent und das Medikament kann bei diesem Patienten nur noch im Notfall eingesetzt werden. Wie du schon im Mikrobiologischen Methodenkurs gelernt hast, dient der Kirby-Bauer-Test dazu, herauszufinden, gegen welche Antibiotika die Erreger des Patienten sensibel bzw. resistent sind. Verwende dann das Lineal, um den Durchmesser des Hemmhofs zu messen.
Trage die gemessenen Werte ein und kreuze an: Gegen welche Antibiotika sind die Erreger bei Lilly Benthaus sensibel bzw. resistent?

Resistenzen:
| Antibiotikum | Resistenzschwelle
(mm) |
Hemmhof-Durchmesser
(mm) |
Aufnahme
sensibel resistent |
| Ciprofloxacin | 26 | ||
| Gentamicin | 15 | ||
| Meropenem | 24 |
Informationen zu den Antibiotika
Bakterien abtötendes Antibiotikum aus der Klasse der Fluorchinolone. Es wirkt durch die Hemmung eines bakteriellen Enzyms, das zum Kopieren der DNA bei der Zellteilung benötigt wird. Es wirkt gut gegen ein breites Spektrum von Bakterien und wird im medizinischen Alltag bei nicht lebensbedrohlichen Infektionen oft eingesetzt. Inzwischen gibt es weltweit viele resistente Stämme verschiedener Erreger.
Bakterien abtötendes Antibiotikum aus der Klasse der Aminoglykoside. Es wirkt durch die Hemmung der Proteinsynthese an den bakteriellen Ribosomen. Es hat ein weniger breites Wirkspektrum als Ciprofloxacin, aber gute Wirkung gegen Pseudomonas aeruginosa. Resistenzen existieren weltweit bei einigen Prozent der Bakterien.
Bakterien abtötendes Antibiotikum aus der Klasse der β-Lactame und damit ein Verwandter des Penicillins. Es wirkt durch die Störung des Aufbaus der bakteriellen Zellwand und deckt ein sehr breites Spektrum von gefährlichen Erregern ab. Gegen Pseudomonas aeruginosa wird es häufig genutzt.
Patientengespräch

Lilly Benthaus
Im Moment geht es mir ganz gut. Ich habe die Pseudomonas-Infektion jetzt seit fast 5 Jahren, aber ich merke kaum etwas davon. Morgens huste ich schon immer ein bisschen was aus, das ist aber nicht mehr geworden. Außerdem gehe ich regelmäßig laufen und da komme ich mit den anderen auch mit, ohne dass mir die Luft knapp wird. Fieber hatte ich in letzter Zeit nicht. Das letzte Mal hatte ich Ciprofloxacin eingenommen, davon ist mir schlecht geworden und ich hatte Hautausschlag. Deshalb möchte ich dieses Antibiotikum nicht noch einmal nehmen.
Tagesbericht – Tag 0 Lilly Benthaus
